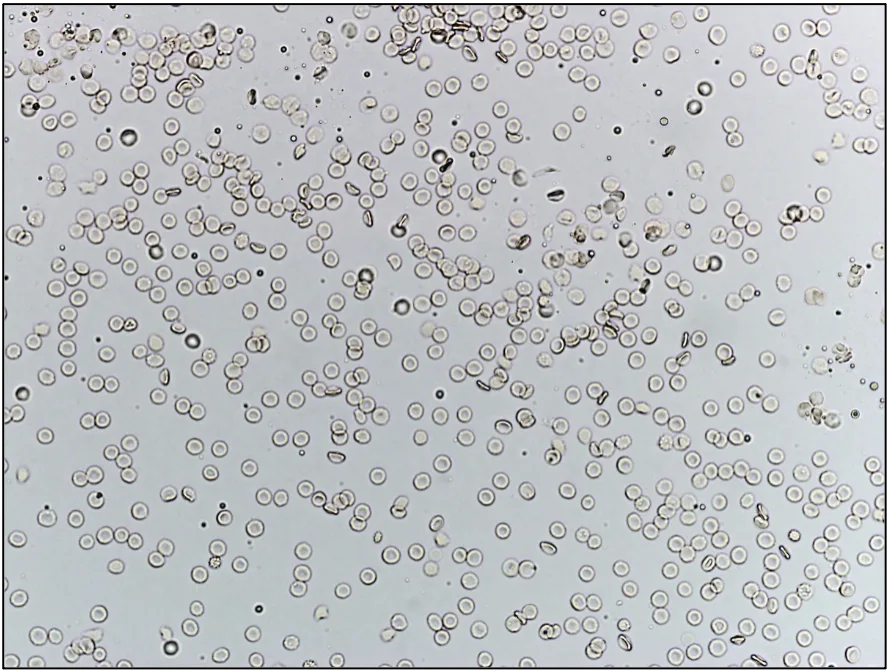
Two unstained urine sediment slides comparing how different urine volumes using the same sample can appear.
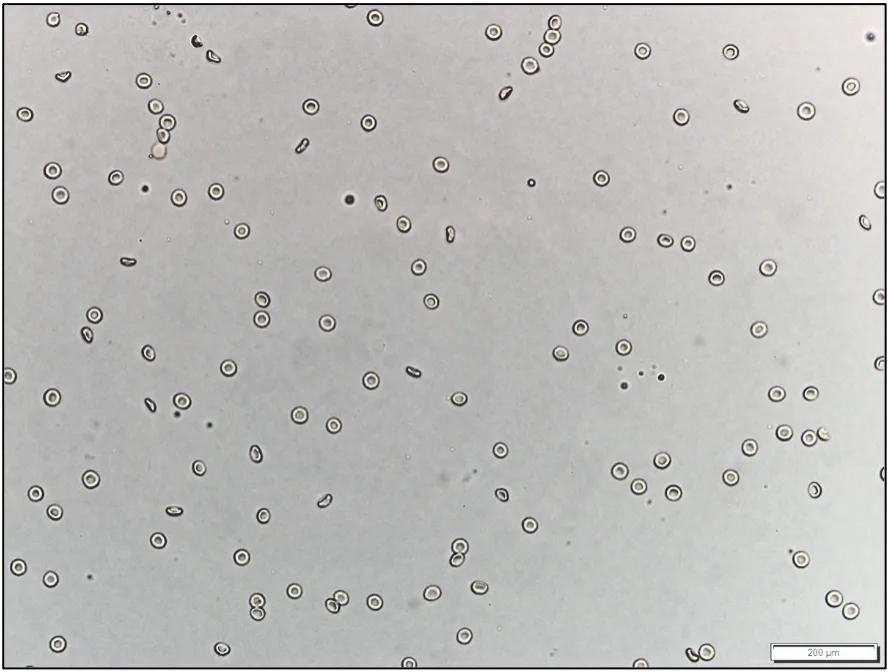
Two unstained urine sediment slides comparing how different urine volumes using the same sample can appear.

Complete urinalysis includes physical, chemical, and microscopic evaluation of urine and provides essential diagnostic information about urinary tract diseases as well as several systemic diseases. Urinalysis is inexpensive, is easily performed in-house, and requires minimal specialized equipment. Although complete urinalysis provides valuable information, this test remains underused in veterinary medicine and is often associated with errors in sample collection, sample handling and storage, and interpretation.1
Following are, in the authors’ opinion, the top 5 errors associated with performing and interpreting urinalysis.
1. Urinalysis Errors Due to Inappropriate Sample Collection Method
Voided sample collection (ie, free catch from the floor or table or into a clean container), cystocentesis, and sterile catheterization are common methods of urine collection in veterinary patients. Each method has advantages and disadvantages (Table), and the individual patient should be considered when choosing a collection technique.1
Table: Advantages & Disadvantages of Urine Collection Methods1
Voided Sample Collection for Urinalysis
A voided sample (ideally midstream) should be collected with the patient urinating directly into a specifically designed and tightly sealable container. Second-use containers should be avoided, as there is potential for contamination with detergents, food residue, or previous contents that can alter urine chemistry analysis.1
Cystocentesis & Sterile Catheterization for Urinalysis
Cystocentesis (preferred) or sterile catheterization should be used when collecting a urine sample for culture and susceptibility testing. Iatrogenic trauma of a blood vessel with the cystocentesis needle can cause a false increase in hemoglobin as well as RBCs in sediment. Protein can be observed with significant blood contamination. Repeated sampling may be needed to determine whether an increase is true or due to collection.2
2. Urinalysis Errors Due to Inconsistent Sample Volume for Centrifugation
A consistent urine volume (eg, 5 mL) should be centrifuged to prepare the sediment.1,2 Centrifugation of different volumes of urine yields different volumes of sediment (Figure 1). Sample volume can therefore significantly impact the number of cells, crystals, and casts detected.1,2 Interpretation may not be accurate when a very small volume of urine is used because reference values (eg, <5 RBCs per high-power field) are based on 5 mL.1

Unstained urine sediment, wet mount. Sediment from centrifugation of 5 mL (A) and 1 mL (B) of the same urine sample, illustrating the importance of using a consistent volume of urine for centrifugation and sediment evaluation. If a consistent volume of urine is not centrifuged, the amount of sediment will vary, as will findings and interpretation.
If collection of adequate volume is not routinely possible, resuspension of all sediment with a constant percentage (eg, 10%) of the volume of centrifuged urine helps minimize artifactual changes associated with volume inconsistency.1 For example, if 1 mL of urine is collected and centrifuged, 0.1 mL of decanted supernatant should be added back to the sediment prior to wet mount evaluation. If 3 mL of urine is collected and centrifuged, 0.3 mL of decanted supernatant should be added back to the sediment prior to wet mount evaluation. If 5 mL of urine is collected—even though this is the desired volume—0.5 mL of supernatant should be added back to the sediment prior to wet mount evaluation to maintain consistency among sample assessments.
3. Urinalysis Errors Due to Inappropriate Timing
Timing of collection and analysis is important but often overlooked.3,4
The complete clinical picture should be considered when determining sample collection timing.3,4 Collection time of day can significantly affect multiple aspects of urinalysis. A sample collected early in the morning, for example, is better for testing tubular ability to concentrate urine, which is important to determine proper kidney function.3 Urine samples should be collected prior to fluid therapy or initiation of diuretics because urine specific gravity (USG) can be falsely decreased, as well as before administration of antibiotics because culture results may be affected. Postprandial samples may exhibit transient alkalinuria.4
Urine analyzed within 1 hour of collection yields the most accurate results. The sample should be placed in a sealed container, refrigerated without exposure to light, and analyzed within 24 hours if assessment is delayed >1 hour.3,4 Refrigerated urine should be brought to room temperature before analysis to avoid an incorrect diagnosis,5 as decreased temperature can cause a false increase in USG measurement and artifactual amorphous crystals in the urine sediment. Delayed examination of urine, especially unrefrigerated samples, can cause numerous artifactual changes, including bacterial overgrowth (pathologic or contaminant); loss of bacterial viability; changes in color; decreased bilirubin, glucose, and ketone concentrations; deterioration of casts and cells; dissolution of crystals; and increased odor, turbidity, and pH.3
4. Urinalysis Errors Due to Inappropriate Use and/or Interpretation of Reagent Strips
Urine can be evaluated semiquantitatively (ie, negative, trace, 1+ to 4+ scale) using commercial reagent strips (dipsticks) that undergo a color change reaction in relation to concentration of an analyte in the sample.1 Reagent strip analysis of urine is standard in veterinary and human medicine. Strips are inexpensive, easy to use, and provide rapid results. Some reagent strip pad assays (eg, USG, leukocyte esterase, nitrites, urobilinogen) are unreliable in veterinary species because they are generally manufactured for use in humans.1,3-6 Leukocyte presence is better determined via sediment evaluation.3 A refractometer provides more reliable readings of USG.1,3,4
Dip vs Drip Method for Reagent Strips
There are contradictory viewpoints on whether reagent strips should be used via the dip or drip method. The dip method consists of briefly (≈1 second) submerging the reagent strip in urine (Figure 2). The drip method consists of directly pipetting urine onto each reagent pad (Figure 3).

The dip method, in which the reagent strip is briefly submerged in urine

The drip method, in which urine is directly pipetted onto each reagent pad
Analysis should be performed per manufacturer instructions for accurate results.3,7,8 The dip method is the only method described in manufacturer guidelines and is preferred.8 Dipping the stick in the urine allows for more uniform wetting of the reagent pad; however, dripping urine on the pad may be more practical when only a small sample volume is available.8 Some reagent pads are designed to absorb urine from the side rather than the top; dipping therefore ensures adequate exposure of the reagents to urine.1
5. Urinalysis Errors Due to Not Considering Patient History During Interpretation
Patient history (eg, diet, drugs) can affect urinalysis results and should be reviewed when abnormal or unexpected findings are identified.
Effect of Diet on Urinalysis Results
Diet (eg, beets, vitamin C, blackberries, rhubarb, carrots, vitamin B, food coloring) can alter urine color; pigmenturia may affect the results of reagent strip test pads and should be considered when reading results.2 Urine pH is highly dependent on diet.9 Alkalinuria is expected in healthy herbivores, whereas aciduria is expected in carnivores and herbivores on a milk diet.1,4
Effect of Medications on Urinalysis Results
Prescription or over-the-counter drugs can also alter urinalysis findings. Administration of fluids or diuretics may falsely decrease USG.10 Dissociative anesthetics (eg, ketamine) can cause glucosuria and hyposthenuria,11 whereas false-negative reactions of blood (heme), bilirubin, and glucose may occur when vitamin C (ascorbic acid) is present.1
Conclusion
As with all diagnostic assays, reliable results depend on the quality and appropriateness of the sample and assessment technique. Appropriate sample collection method, volume, timing, and technique, as well as awareness of patient history, can help ensure effective and efficient patient care.